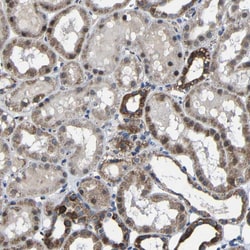
Invitrogen Carbonic Anhydrase VB Polyclonal Antibody 100 &mu;L; Unconjugated:Antibodies,

missing translation for 'onlineSavingsMsg'
Learn More
Learn More
Description
Immunogen sequence: GLAVIGVFLK LGKHHKELQK LVDTLPSIKH KDALVEFGSF DPSCLMPTCP DYWTYSGSLT TPPLSESVTW IIKKQPVEVD HDQLEQFRTL LFTSEGEKEK RMVD Highest antigen sequence identity to the following orthologs: Mouse - 98%, Rat - 98%.
Carbonic anhydrases (CAs) are members of a large family of zinc metalloenzymes responsible for catalyzing the reversible hydration of carbon dioxide.CAs show extensive diversity in their distribution and subcellular localization.They are involved in a variety of biological processes, including calcification, bone resorption, respiration, acid-base balance and the formation of aqueous humor, saliva, gastric juice and cerebrospinal fluid. CA VB, also known as carbonate dehydratase VB, is one of two isoforms of CA V. It localizes to the mitochondria and is involved in metabolic processes. CA VB is predominantly expressed in heart, pancreas, lung, placenta, kidney and skeletal muscle. It exhibits highest homology with family member CA VA (the second isoform of CA V); however, unlike CA VA, it is not expressed in the liver, suggesting that it plays a significantly different physiological role.

Specifications
Specifications
| Antigen | Carbonic Anhydrase VB |
| Applications | Immunohistochemistry (Paraffin), Western Blot, Immunocytochemistry |
| Classification | Polyclonal |
| Concentration | 0.1 mg/mL |
| Conjugate | Unconjugated |
| Formulation | PBS with 40% glycerol and 0.02% sodium azide; pH 7.2 |
| Gene | CA5B |
| Gene Accession No. | Q9Y2D0 |
| Gene Alias | 7330410H16Rik; Ca5b; Car5b; Carbonate dehydratase VB; carbonic anhydrase 5B; carbonic anhydrase 5b, mitochondrial; Carbonic anhydrase VB; carbonic anhydrase VB, mitochondrial; carbonic dehydratase; CarVb; CAVB; CA-VB; D730005F19Rik |
| Gene Symbols | CA5B |
| Show More |
Product Title
By clicking Submit, you acknowledge that you may be contacted by Fisher Scientific in regards to the feedback you have provided in this form. We will not share your information for any other purposes. All contact information provided shall also be maintained in accordance with our Privacy Policy.
Spot an opportunity for improvement?